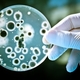
Bio156

-
Link text
The chain of being is composed of many hierarchical links, from the most basic and fundamental elements making up matter all the way to epitome of perfection which is God. -
Link text Very knowledgeable medical researchers of old times (Roman Empire) Galens theories influenced the medical field for more than 1300 years. These thoeries included anatomy, physiology, pathology, pharmacology, and neurology, as well as philosophy and logic.
-
Link text The germ theory of disease says some diseases are caused by microorganisms. These small organisms are too small to see with the naked eye and invade humans, animals, and other living hosts. The germ theory was proposed by Girolamo Fracastoro in 1546 but not until late 1850s was it starting to get embraced as the work of Louis Pasteur and Robert Koch provided convincing evidence.
-
Link text Acquired characteristics by means of inheritance is a hypothesis that physiological changes acquired over the life of an organism (Like the repeated use of a brain for higher learning and more complex computation would result in slightly larger brain which in turn could be passed down to descendants) Lamarck published his theory in 1809, the year Charles Darwin was born. LoL
-
Link text The book written by Charles Darwin and published in 1839 as a vivid and exciting travel memoir as well as a detailed scientific field journal covering biology, geology, and anthropology that demonstrates Darwin's keen powers of observation.
-
Link text Pasteur invented the swan-necked flask to create an environment known not to grow microorganisms. After sterilizing a nutrient broth in these flasks, he removed the swan necks of the samples in the control group. Microorganisms grew in the control group, but not the experimental group, supporting biogenesis and rejecting spontaneous generation.
-
Link text We got the terms “recessive” and “dominant” from Mendels pea plant experiments in reference to certain traits. (In the preceding example, green peas are recessive and yellow peas are dominant.) Mendel shows how invisible “factors”—now called genes—in providing for visible traits in predictable ways now known as the laws of Mendelian inheritance.
-
Link text The result of the Challenger Expedition was the Report Of The Scientific Results of the Exploring Voyage of H.M.S. Challenger during the years 1873-76 which, among many other discoveries, cataloged over 4,000 previously unknown species. On March 23, 1875 the Challenger discovered the area that represents the southern end of the Mariana trench and is one of the deepest known places on the ocean floor.
-
Link text Plasmodium falciparum is a protozoan parasite, one of the species of Plasmodium that cause malaria in humans. It is transmitted by the female Anopheles mosquito. This species causes the disease's most dangerous form, malignant or falciparum malaria.
-
Link text The equation is an expression of the principle known as Hardy-Weinberg equilibrium, which states that the amount of genetic variation in a population will remain constant from one generation to the next in the absence of disturbing factors.
-
Link text The Bohr model of an atom depicts the atom as a small, positively charged nucleus surrounded by electrons that travel in circular orbits around the nucleus—similar in structure to the Solar System, but with attraction provided by electrostatic forces rather than gravity. Even though the Bohr model has been improved upon, it helped to guide us to the modern quantum mechanical model of the atom we use today.
-
Link text Griffith's experiments were the first experiments to suggesting that bacteria was capable of transferring genetic information through a process known as transformation.
-
-
Link text Thomas Hunt Mogan fruit fly discoveries show us what roles the chromosome plays in heredity. His discoveries formed the basis of the modern science of genetics.
-
Link text This book explains evolution in depth as a process over time that accounts for the diversity of all life on Earth
-
Link text The one gene-one enzyme hypothesis is the idea that genes act through the production of enzymes, with each gene responsible for producing a single enzyme that in turn affects a single step in a metabolic pathway. This hypothesis has come to be regarded as oversimplified for the actual relationship between genes and proteins
-
Link text The biological species concept is the most widely accepted species concept. It defines species in terms of interbreeding. The biological species concept explains why the members of a species resemble one another, i.e. form phenetic clusters, and differ from other species.
-
-
Link text Experiments showing that it was DNA rather than some small amount of RNA, protein, or some other cell component that was responsible for carrying genetic information.
-
Link text A series of experiments conducted in 1952 by Alfred Hershey and Martha Chase that helped to confirm that DNA is genetic material.
-
Link text The experiments were chemical experiment that simulated the conditions scientists thought at the time to be present on the early Earth, and tested the chemical origin of life under those conditions. More-recent evidence suggests that Earth's original atmosphere might have had a different atmospheric composition from the gas used in the Miller experiment.
-
Link text Photograph 51 is the nickname given to an X-ray diffraction image of DNA taken by Raymond Gosling in May 1952, working as a PhD student under the supervision of Rosalind Franklin.
-
nature.com
history.com
wikipedia.org On this day in 1953, Cambridge University scientists James D. Watson and Frances H.C. Crick announce that they have determined the double-helix structure of DNA, the molecule containing human genes. -
Link text
Ensatina eschscholtzii has been described as a ring species due to its inability to interbread with the Ensatina klauberi. Ensatina eschscholtzii is thought to be an example of incipient speciation. -
Link text
Link text Writings from Alfred Russel Wallace were jointly published with some of Charles Darwin's writings in 1858. Wallace published similar theories to those of Charles Darwin a year before Charles Darwin published "The Origin of Species" Even though we credit mostly Charles Darwin, Charles probably got some of his ideas from Wallace. -
Link text Hypothesis that DNA replication was semiconservative. When the double stranded DNA helix is replicated, each of the two new double-stranded DNA helices consisted of one strand from the original helix and one newly synthesized. Meselson and Stahl decided to use an isotope of nitrogen to distinguish parent and newly copied DNA. The isotope of nitrogen had an extra neutron in the nucleus, which made it heavier
-
Link text This scientific work of literature by Charles Darwin is considered to be the foundation of evolutionary biology. Darwin's book introduced the scientific theory that populations evolve over the course of generations through a process of natural selection. It presented a body of evidence that the diversity of life arose by common descent through a branching pattern of evolution. *Survival of the fittest
-
Link text The experiment cracked the genetic code by using nucleic acid homopolymers to translate specific amino acids.
-
Link text Endosymbiosis theory- organelles distinguishing eukaryote cells evolved from symbiosis of individual single-celled prokaryotes (bacteria and archaea) The endosymbiosis theory of organogenesis became widely accepted in the 1980s, when the genetic material of mitochondria and chloroplasts was found to be different from that of the symbiont's nuclear DNA
-
Link text First manned lunar landing. Neil Armstrong and pilot Buzz Aldrin stepped on the moon.
-
Link text "Nothing in Biology Makes Sense Except in the Light of Evolution" is an essay written by the evolutionary biologist and Eastern Orthodox Christian Theodosius Dobzhansky, criticising anti-evolution creationism. One of Dobzhansky main ideas in his work is that scripture and science are two different things.
-
Link text Lucy fossils are about 40 percent of the skeleton of a female of the hominin species Australopithecus afarensis which is an early tree-dwelling australopithecine and is dated to about 3.2 million years ago. The skeleton presents a small skull akin to that of non-hominin apes, plus evidence of a walking-gait that was bipedal and upright, akin to that of humans (and other hominins).
-
Link text Sanger sequencing is a method of DNA sequencing developed by Frederick Sanger and colleagues in 1977, it was the most widely used sequencing method for approximately 39 years.
-
Link text Hydrothermal vent is a fissure in a planet's surface from which geothermally heated water issues.Relative to the majority of the deep sea, the areas around submarine hydrothermal vents are biologically more productive, often hosting complex communities fueled by the chemicals dissolved in the vent fluids
-
Link text spliceosome is a large and complex molecular machine found primarily within the splicing speckles of the cell nucleus. This split gene is a type of primary transcript.
-
Link text
Link text Kary Mullis was able to amplify a single copy or a few copies of DNA into thousands or millions of copies of a particular DNA sequence. It is an easy and cheap tool to amplify a focused segment of DNA, useful for such purposes as the diagnosis and monitoring of genetic diseases, identification of criminals, and studying the function of a targeted segment of DNA. -
-
Speculation, the main factor in defining species is reproductive isolation. Two main categories of reproductive isolation are prezygotic and postzygotic. Two main divisions are premating isolation, in which mating is prevented from occurring, and postmating isolation, in which mating takes place but viable, fertile offspring are not produced.
-
Link text The Innocence Project is a non-profit that works to exonerating wrongly convicted people through the use of DNA testing as well as scientific means.
-
-
Link text Sahelanthropus tchadensis is one of the oldest known species in the human family tree. This species lived sometime between 7 and 6 million years ago in West-Central Africa (Chad). Walking upright may have helped this species flourish. Studies so far show the species had a combination of ape-like and human-like features.
-
Link text In March 2010, scientists announced the discovery of a finger bone fragment of a juvenile female who lived about 41,000 years ago, found in the remote Denisova Cave in the Altai Mountains in Siberia, a cave that has also been inhabited by Neanderthals and modern humans.
-
-
Link text
Link text
)
CRISPR associated protein 9- Cas9 protein has been heavily utilized as a genome engineering tool to induce site-directed double strand breaks in DNA. These breaks can lead to gene inactivation or the introduction of heterologous genes. This would allow us to change dna genomes and remove or introduce new desired traits. -
The human genome is fully sequenced- determining the exact order of the base pairs in a segment of DNA. This is not the rough draft published on June 26, 2000 In the final version there are less than 400 gaps and 99 percent of the genome is finished with an accuracy rate of less than one error every 10,000 base pairs.
Link text
Link text
Want to make a timeline like this?
Use Timetoast to turn dates, events, milestones, and phases into a clear visual timeline you can build and share. Timetoast is a timeline maker for work, school, research, and stories.